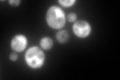
YPL037C
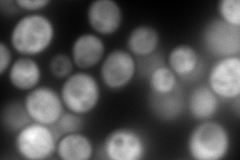
YPL037C
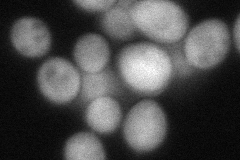
YPL037C
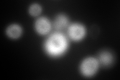
YPL037C
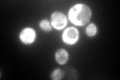
YPL037C

View description
Subunit beta1 of the nascent polypeptide-associated complex (NAC) involved in protein targeting, associated with cytoplasmic ribosomes; enhances DNA binding of the Gal4p activator; homolog of human BTF3b
Localization:
Intensity:
Fold change:
Significance:
-
C’ GFP library in SD
cytosol608.66 -
N' NOP1pr-GFP in SD

cytosol255.062 -
N' TEF2pr-mCherry in SD
cytosol565.861 -
N' NATIVEpr-GFP in SD

cytosol111.95 -
N' TEF2pr-VC and Cyto-VN in SD
cytosol80.5149 -
C’ GFP library in SD+DTT
cytosol599.860.98No -
C’ GFP library in SD+H2O2

cytosol608.661No -
C’ GFP library in Starvation Media
cytosol519.380.85No -
C’ GFP library on the background of Pup2-DaMP

cytosol -
C’ GFP library on the background of CCT mutant

cytosol344.9670.566755Yes
